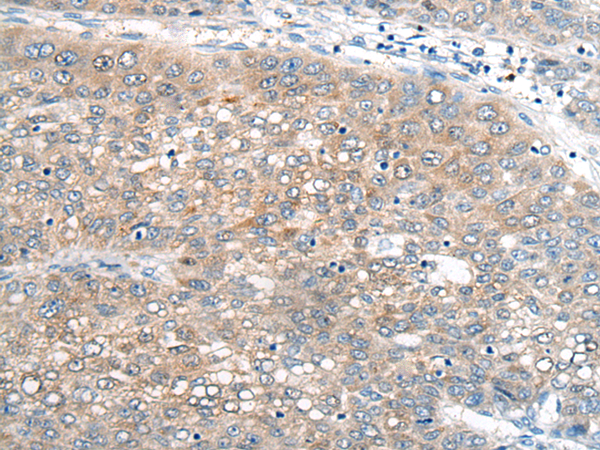

-
分类: 科研抗体货号: P02344别名: UBC12; hUbc12; UBC-RS2应用: WB,IHC反应种属: Human, Mouse
-
分类: 科研抗体货号: P02279别名: ZNF690; Zfp690应用: IHC反应种属: Human
-
分类: 科研抗体货号: P02343别名: UBCH10; dJ447F3.2应用: WB,IHC反应种属: Human, Mouse
-
分类: 科研抗体货号: P02272别名: APA1; APA-1应用: IHC反应种属: Human
-
分类: 科研抗体货号: P02340别名: UBC7应用: WB,IHC反应种属: Human, Mouse
-
分类: 科研抗体货号: P02268别名: JAZ; Zfp346应用: WB,IHC反应种属: Human, Mouse
-
分类: 科研抗体货号: P02338别名: FANCT; PIG50; HSPC150应用: IHC反应种属: Human, Mouse
-
分类: 科研抗体货号: P02267别名: KOX32应用: WB,IHC反应种属: Human
-
分类: 科研抗体货号: P02323别名: VTI1; VTI2; VTI1L; v-SNARE; vti1-rp1; VTI1-LIKE应用: WB,IHC反应种属: Human, Mouse, Rat
-
分类: 科研抗体货号: P02255别名: BuGZ; hBuGZ应用: WB,IHC反应种属: Human, Mouse

鄂公网安备42018502007531号
鄂公网安备42018502007531号

